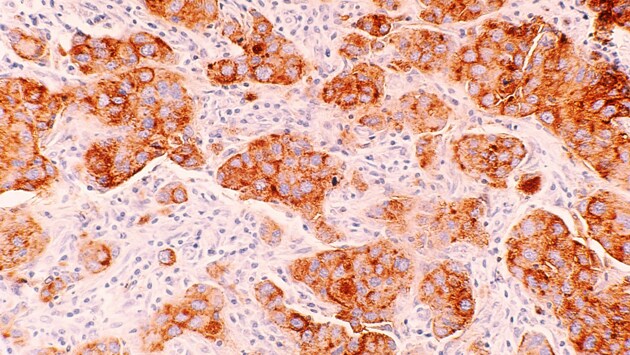

Российские учёные сделают лечение рака безопасней
В России разработают устройство для контроля нагрева во время микроволновой терапии рака
Специалисты Сеченовского университета начали разработку нового устройства, которое поможет более точно контролировать температуру тканей при проведении микроволновой абляции. Эта технология используется для лечения опухолей, и новинка должна помочь снизить риск осложнений, связанных с перегревом окружающих тканей. Устройство будет измерять температуру сразу в трёх зонах воздействия, что позволит выбирать оптимальный режим для уничтожения опухолевых клеток.
Микроволновая абляция (МВА) — это современный метод, при котором с помощью зонда СВЧ излучения нагревают опухоль до 120 градусов Цельсия, разрушая клетки. Важно правильно контролировать температуру, чтобы достичь нужного эффекта, не повредив здоровые ткани. Существующие приборы, такие как термопары, измеряют температуру только в одной точке, что ограничивает их точность и эффективность, объяснил доцент кафедры факультетской хирургии Максим Салиба. Новый прибор, разрабатываемый специалистами, должен решить эту проблему.
В настоящий момент уже создан тестовый образец устройства, и его дальнейшее развитие продолжается. Прототип планируют закончить к концу 2025 года, чтобы провести полноценные экспериментальные исследования и внедрить технологию в клиническую практику.